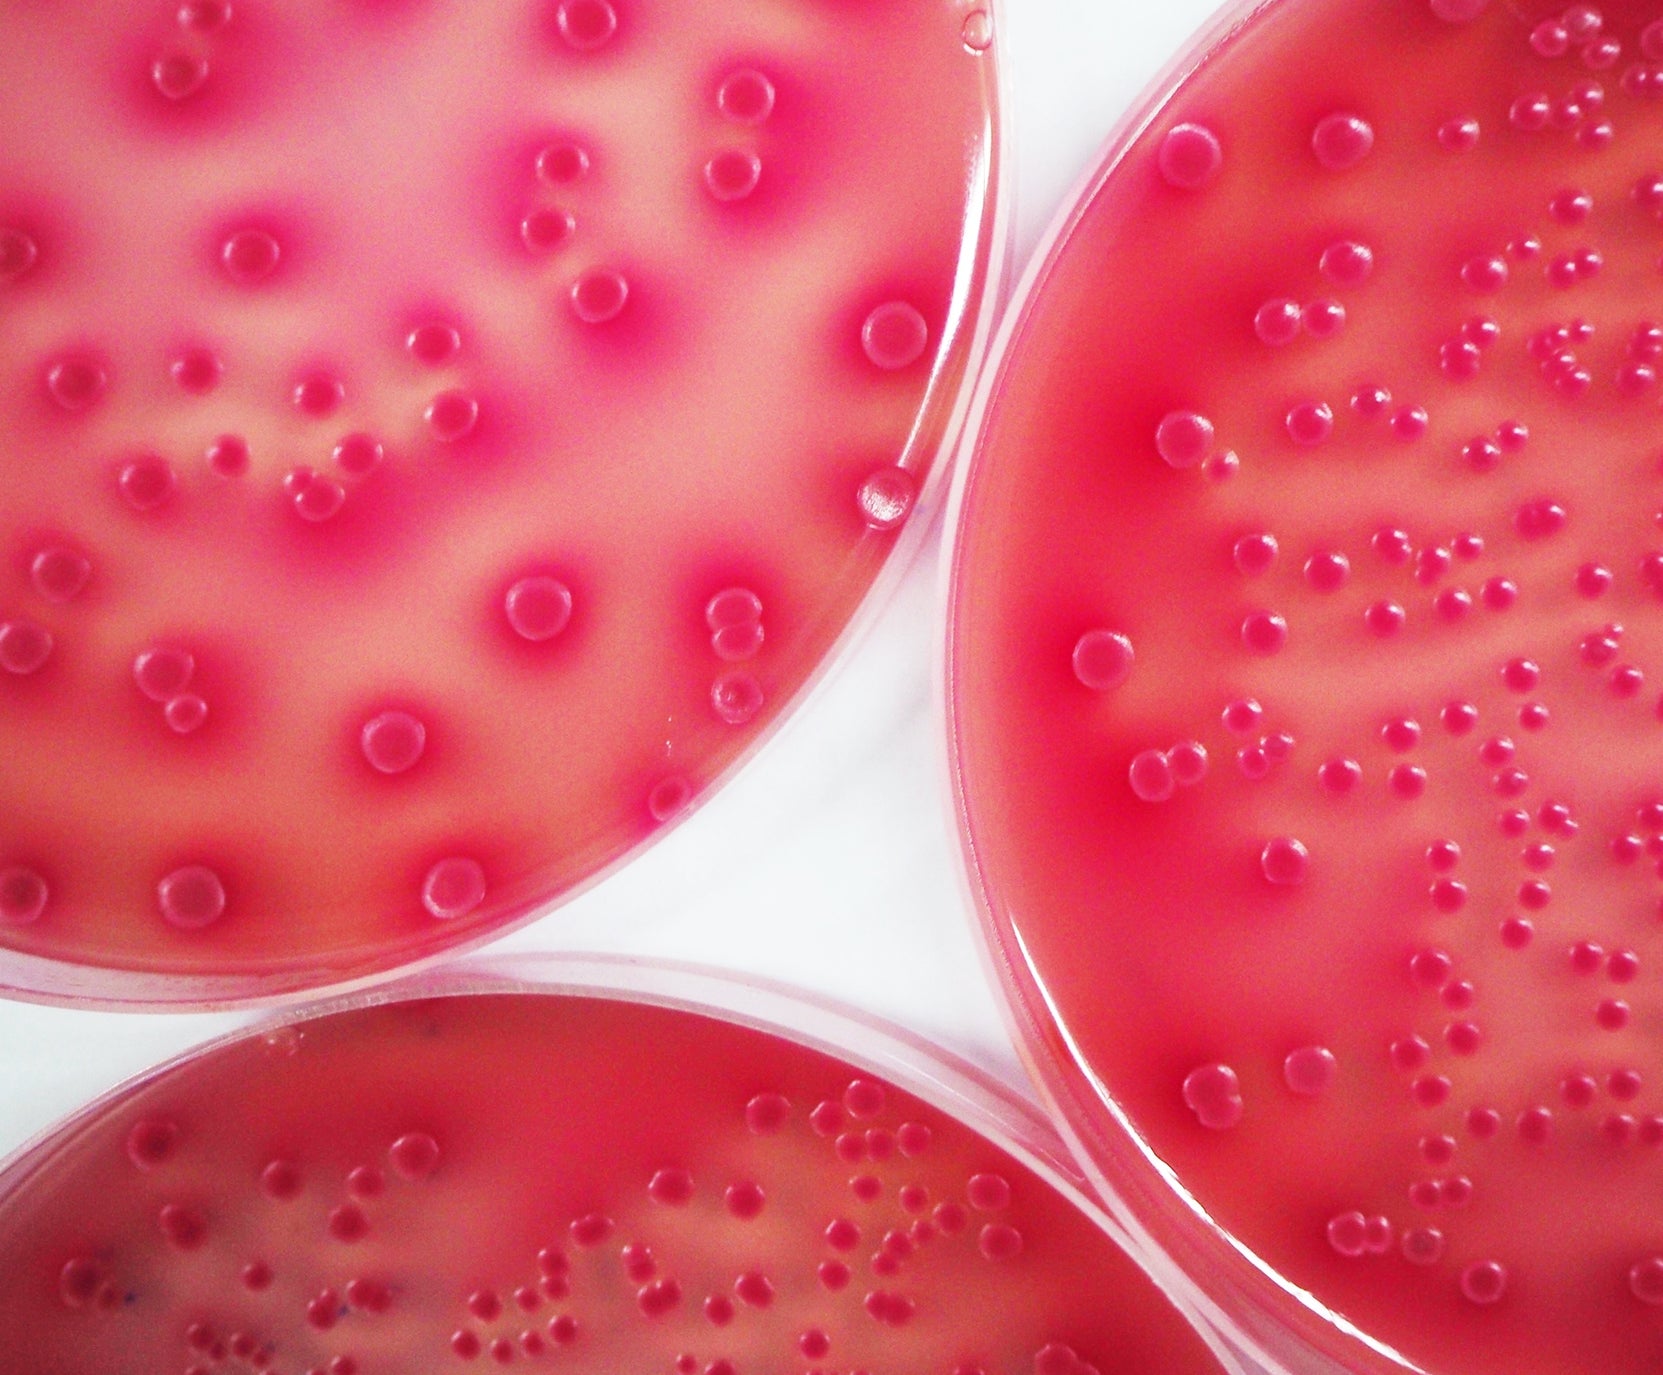

Better Science to Solve the World’s Toughest Preservation Challenges
Our solutions, our expertise and our support help our customers to work better - to be more efficient, more effective, more sustainable.
Microbial Control Solution
Nutrition, Care & Environmental
How can we support your business?